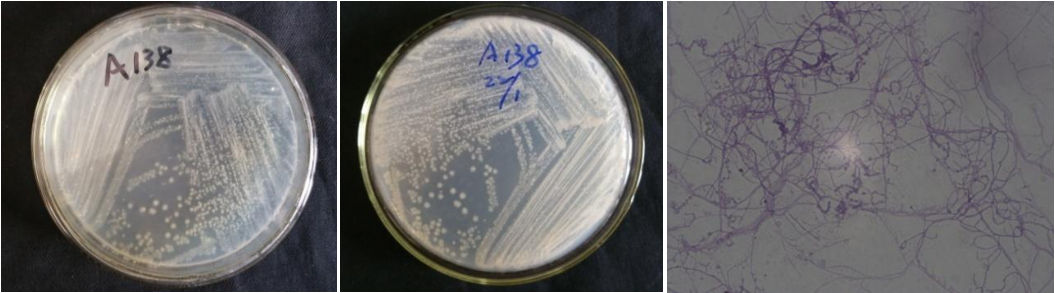

Loading...
| StrainNO | A138 |
| Classification | Amycolatopsis |
| 16s rDNA sequence | ACGCTGGCGGCGTGCTTAACACATGCAAGTCGAACGATGAAGCCTTCGGGTGGATTAGTGGCGAACGGGTGAGTAACACGTGGGT AATCTGCCCTGTACTCTGGGATAAGCCTTGGAAACGGGGTCTAATACCGGATATCACCGACTCTCGCATGGGGGTTGGTTGAAAG TTTCGGCGGTRCAGGATGAGCCCGCGGCCTATCAGCTTGTTGGTGGGGTGATGGCCTACCAAGGCGACGACGGGTAGCCGGCCTG AGAGGGTGACCGGCCACACTGGGACTGAGACACGGCCCAGACTCCTACGGGAGGCAGCAGTGGGGAATATTGCACAATGGGCGGA AGCCTGATGCAGCGACGCCGCGTGAGGGATGACGGCCTTCGGGTTGTAAACCTCTTTCGCCAGGGACGAAGCGCAAGTGACGGTA CCTGGATAAGAAGCACCGGCTAACTACGTGCCAGCAGCCGCGGTAATACGTAGGGTGCGAGCGTTGTCCGGATTTATTGGGCGTA AAGAGCTCGTAGGCGGTTTGTCGCGTCGTTCGTGAAAACTCCACGCTTAACGTGGAGCGTGCGGGCGATACGGGCAGACTTGAGT TCGGTAGGGGAGACTGGAATTCCTGGTGTAGCGGTGAAATGCGCAGATATCAGGAGGAACACCGGTGGCGAAGGCGGGTCTCTGG GCCGATACTGACGCTGAGGAGCGAAAGCGTGGGGAGCGAACAGGATTAGATACCCTGGTAGTCCACGCTGTAAACGTTGGGCGCT AGGTGTGGGTGACATTCCACGTTGTCCGTGCCGTAGCTAACGCATTAAGCGCCCCGCCTGGGGAGTACGGCCGCAAGGCTAAAAC TCAAAGGAATTGACGGGGGCCCGCACAAGCGGCGGAGCATGTGGATTAATTCGATGCAACGCGAAGAACCTTACCTGGGCTTGAC ATGCACTGGAAACCAGTAGAGATATTGGCCCCCTTGTGGCCGGTGTACAGGTGGTGCATGGCTGTCGTCAGCTCGTGTCGTGAGA TGTTGGGTTAAGTCCCGCAACGAGCGCAACCCTTATCCTACGTTGCCAGCAAGTAAAGTTGGGGACTCGTGGGAGACTGCCGGGG TCAACTCGGAGGAAGGTGGGGATGACGTCAAGTCATCATGCCCCTTATGTCCAGGGCTTCACACATGCTACAATGGCTGGTACAG AGGGCTGCGATACCGCGAGGTGGAGCGAATCCCTTAAAGCCGGTCTCAGTTCGGATCGCAGTCTGCAACTCGACTGCGTGAAGTC GGAGTCGCTAGTAATCGCAGATCAGCAACGCTGCGGTGAATACGTTCCCGGGCCTTGTACACACCGCCCGTCACGTCATGAAAGT CGGTAACACCCGAAGCCCATGGCCCAACCCTTCGGGGAGGGAGTGGTCGAAGGTGG |
| Strain Morphology Photos | |
| Morphological Description |